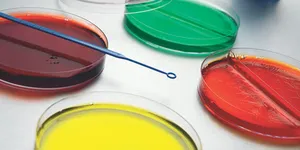
MÔI TRƯỜNG NUÔI CẤY (CULTURE MEDIUM) VI SINH

THEO DÕI NHIỆT ĐỘ VACCINE - COVID 19
24/07/2021
Có nhiều sản phẩm nhạy cảm với nhiệt độ được phân phối bằng “Cold Chain” (chuỗi cung ứng lạnh), một dây chuyền làm lạnh từ nơi sản xuất đến người tiêu dùng. Vaccine đặc biệt nhạy cảm với nhiệt độ trong chuỗi cung ứng lạnh, vì: Tác động làm hỏng vaccine do kiểm soát nhiệt độ kém, có khả năng nguy hiểm tới tính mạng. Nó có thể khó hoặc không thể phát hiện bằng mắt thường khi vắc xin không hoạt động do được bảo quản ở nhiệt độ không thích hợp. Chuổi cung ứng phức tạp
Xem thêm ››
Phân biệt Thanh Trùng và Tiệt Trùng
24/07/2021
Sự hình thành của quá trình tiệt trùng và thanh trùng Trong nhiều thế kỷ trước đây, việc bảo quản thực phẩm là điều rất khó khăn và rất bí ẩn. Con người phải dùng nhiều thủ thuật khác nhau để bảo quản thịt, cá, trái cây, rau,… và các loại thực phẩm khác. Tất cả đều dựa trên thực nghiệm và kinh nghiệm trực tiếp và kết quả không phải lúc nào cũng như mong muốn.
Xem thêm ››
Cốc đốt thấp thành – Đặc điểm và nên mua ở đâu uy tín?
24/07/2021
Cốc đốt là dụng cụ không thể thiếu trong các phòng thí nghiệm. Cốc đốt có 2 loại là cốc đốt cao thành và cốc đốt thấp thành. Trong đó, cốc đốt thấp thành được sử dụng rộng rãi và phù hợp với các nghiên cứu, các ứng dụng có nhiệt độ cao trong phòng thí nghiệm.
Xem thêm ››
CÁCH DÙNG NHIỆT KẾ LÒ NƯỚNG
24/07/2021
Bạn cho rằng sau khi cho vào lò nướng thì chỉ cần đợi bánh chín là xong? Tuy nhiên nếu không biết nhiệt độ lò nướng như thế nào thì có thể bạn sẽ phải thưởng thức chiếc bánh chưa chín hay chín quá. Một vật dụng không thể thiếu cho khâu cuối cùng này là chiếc nhiệt kế lò.
Xem thêm ››
Thời gian và nhiệt độ chuẩn của các mức độ Beefsteak
24/07/2021
Beefsteak - Bít tết bò, món ăn phổ biến và khá được ưa thích trong những năm gần đây. Món ăn này khá không chỉ đáp ứng về mặt khẩu vị mà nó còn đáp ứng nhu cầu về mặt dinh dưỡng cho người sử dụng. Đối với những người sành ăn thì họ khá chú trọng đến nhiệt độ của từng cấp độ bít tết.
Xem thêm ››
ỨNG DỤNG CỦA NƯỚC CẤT TRONG CUỘC SỐNG
24/07/2021
Ứng dụng của nước cất ngày càng phổ biến trong cuộc sống. Nhưng ít ai biết rằng, nước cất được tạo ra như thế nào, có đặc tính ra sao và ứng dụng cụ thể vào lĩnh vực nào. Bài viết này sẽ chia sẻ chuyên sâu về vấn đề nước cất và ứng dụng nước cất trong công nghiệp, nông nghiệp, khoa học ứng dụng.
Xem thêm ››
4 lợi ích của máy đo ph cầm tay
24/07/2021
Máy đo pH hiện nay có nhiều loại và nhiều kiểu dáng khác nhau, có loại để bàn, có loại cầm tay,... nhưng thường máy đo pH cầm tay được nhiều người sử dụng hơn. Vậy “Máy đo pH Cầm Tay Có Những Lợi Ích Gì?” cùng chúng tôi tìm hiểu chi tiết hơn thông qua bài viết sau nhé!
Xem thêm ››
Nguyên lý hoạt động của cân sấy ẩm
24/07/2021
Nguyên lý hoạt động của cân sấy ẩm dựa trên nguyên tắc trọng lực gia nhiệt giúp mang lại hiệu quả sấy nhanh, cân trọng lượng chính xác, tiết kiệm thời gian.
Xem thêm ››
Vì sao hạt hút ẩm đổi màu?
24/07/2021
Hạt hút ẩm là một sản phẩm quan trọng trong việc bảo quản các sản phẩm công nghiệp cũng như thực phẩm, chúng ta bắt gặp chúng ở nhiều nơi trong cuộc sống với nhiều dạng và màu sắc khác nhau, có loại hạt trắng, có loại hạt màu xanh, màu vàng hay màu nâu…vv. và chúng đổi màu khi no nước vì sao vậy?
Xem thêm ››
HÓA CHẤT HIMEDIA
22/07/2021
Hãng hoá chất Himedia Ấn Độ được cung cấp tại thị trường Việt Nam. Himedia với giá cả cạnh tranh so với các đối thủ nặng ký trên thị trường. Himedia đặc biệt nổi tiếng với khả năng cung cấp môi trường vi sinh, Himedia xếp hạng là một trong những công ty chuyên về môi trường vi sinh trên thế giới.
Xem thêm ››
MÔI TRƯỜNG NUÔI CẤY (CULTURE MEDIUM) VI SINH
22/07/2021
Môi trường nuôi cấy vi sinh là gì? Môi trường nuôi cấy vi sinh là các cơ chất dinh dưỡng được pha chế nhân tạo nhằm đáp ứng cho yêu cầu sinh trưởng, phát triển và sản sinh các sản phẩm trao đổi chất của vi sinh vật. Môi trường dinh dưỡng dùng trong nghiên cứu vi sinh vật và trong quá trình sản xuất các sản phẩm của vi sinh vật. Môi trường dinh dưỡng là yếu tố quan trọng trong công nghiệp lên men, công nghiệp sinh tổng hợp nhờ vi sinh vật.
Xem thêm ››
NHIỆT ĐỘ PHA SỬA CHO BÉ BAO NHIÊU LÀ PHÙ HỢP?
22/07/2021
- Nhiều nghiên cứu đã chứng minh, nếu pha sữa bột bằng nước nóng ở nhiệt độ từ 60 đến 80 độ C thì một số thành phần dinh dưỡng trong sữa bị biến chất. Nhiệt độ thích hợp nhất để pha sữa cho bé là nước ở 40 độ C. Một số sữa có chứa một lượng nhỏ vitamin rất nhạy cảm với nhiệt. Nhiệt độ cao sẽ phá hủy các cấu trúc của các vitamin, làm mất chất dinh dưỡng có trong sữa. Các loại sữa công thức có bổ sung lợi khuẩn probiotic nếu pha nước nhiệt độ quá nóng cũng làm giết chết các lợi khuẩn này.
Xem thêm ››
